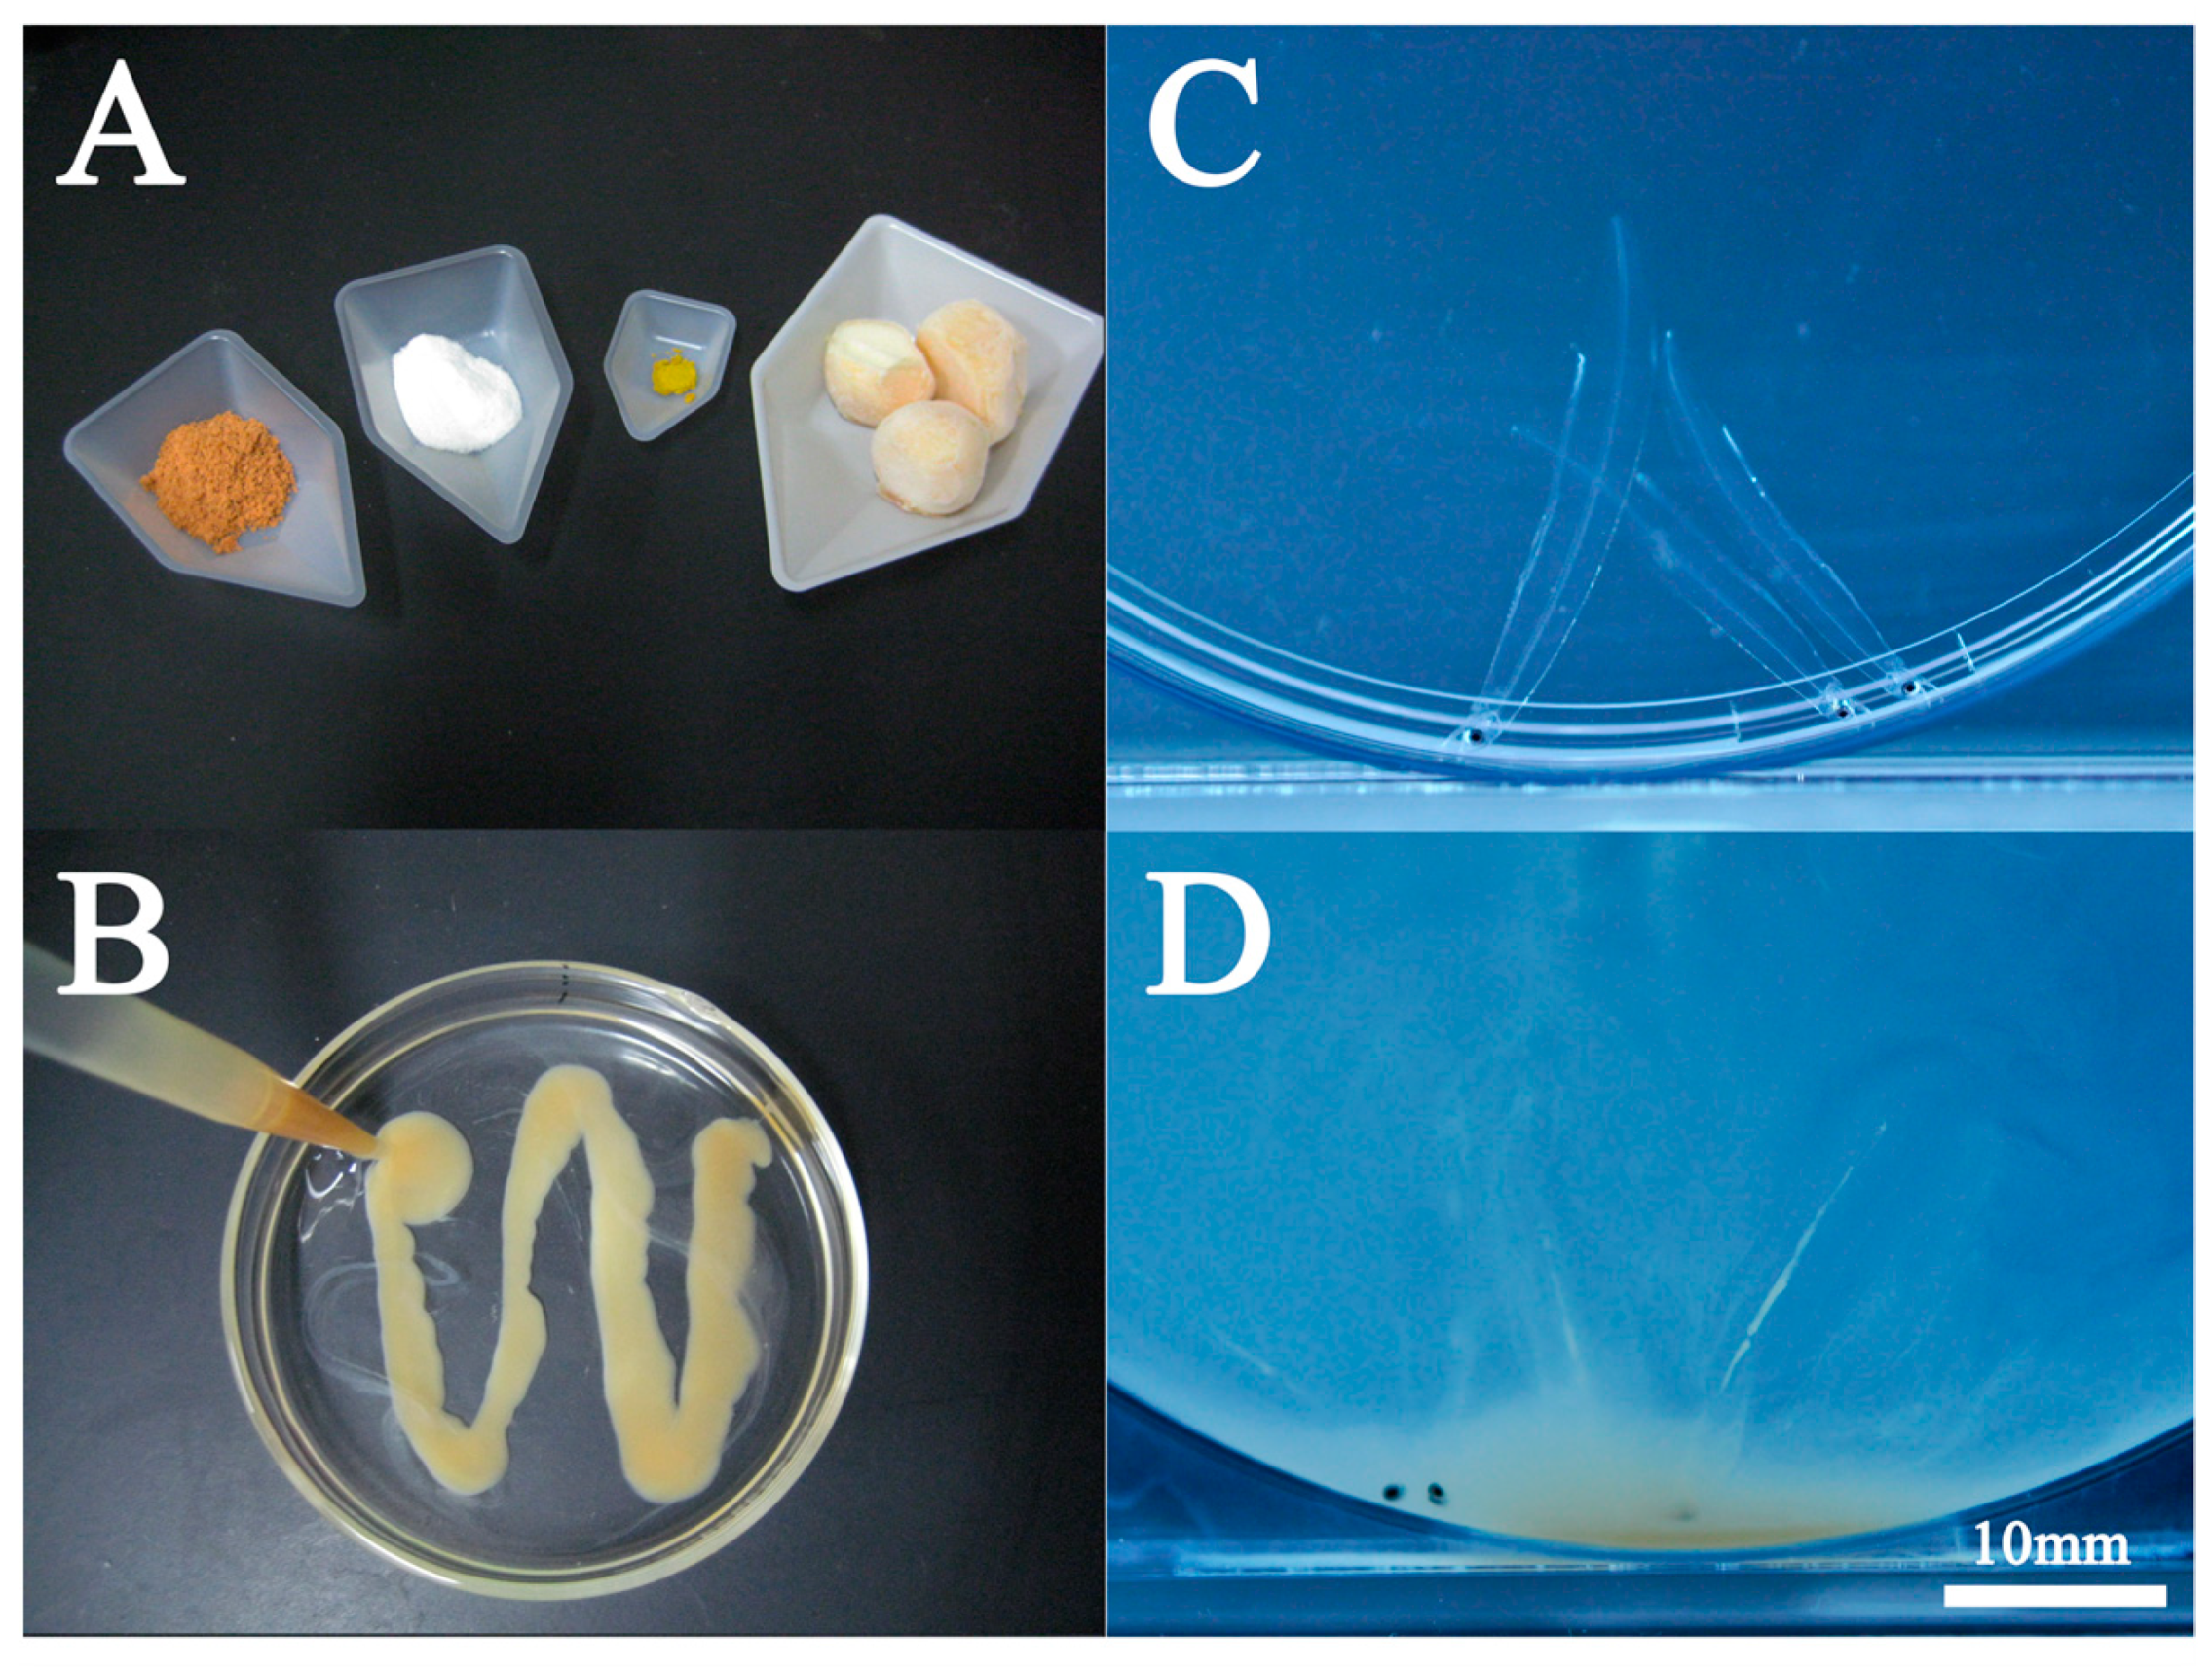
Preprints 89229 g007

1. Introduction
Anguilliformes, a group of eel-shaped fish, encompasses three suborders, 15 families, and 141 genera (Nelson, 2006). One striking feature of Anguilliformes is their larvae, known as leptocephali, the body is transparent, narrow with a high back, and has a leaf shape (Tesch, 1977); the body also has a high content of water and glycosaminoglycans, mainly hyaluronic acid (hyaluronan, HA) (Kawakami et al., 2009, Pfeiler et al., 2002). In the transition of leptocephali to elvers, which have the eel shape, Anguilliformes undergo drastic changes in a process termed metamorphosis (Kawakami et al., 2009, 2013, 2023).
The Japanese eel (
Anguilla japonica) spawns in the western Mariana Islands, with leptocephali transported westward by the North Equatorial Current (Tsukamoto, 1992). Although data on metamorphosing leptocephali remain limited, the metamorphosis occurs in the eastern waters of Taiwan and the Philippines, with the resulting larvae immigrating to China, Taiwan, and the Korean Peninsula as glass eels (e.g., Kawakami et al., 1999a, 1999b) (
Figure 1). There are two probable immigration routes to Japan: glass eels are transported northward along the Pacific coast via the Kuroshio Current, while on the Sea of Japan side, they transition from the Kuroshio Current to the Tsushima Current (Kawakami et al., 1999a, 1999b). Therefore, the dispersal of glass eels influences the distribution of Japanese eels in East Asia.
Japanese eels have been eaten for a long time, especially in Japan. Despite its significance in Japanese freshwater aquaculture, seedling production still relies heavily on wild glass eels. Thus, the development of artificial seedling production technology has become a crucial research endeavor in Japan, tantamount to a national project. Research and development in Japanese eel seedling production began in the 1960s with the induction of sexual maturation to obtain fertilized eggs (Ijiri et al., 2011). Although artificial hatching and few-week old larvae were reported in 1974 (Yamamoto and Yamauchi, 1974), techniques for larval rearing were not extensively researched for an extended period.
The production of artificial glass eel seedlings was first reported in 2002 (Tanaka et al, 2003), and by 2010, full-cycle aquaculture had been achieved (Tanaka, 2015). Several generations of artificial eels have been produced through successive rearing. The established rearing methods from the 1990s, including the use of artificial feed based on shark eggs (Tanaka et al., 2001), have since evolved, with a shift away from shark eggs toward hen egg yolk-based feed (Okamura et al., 2013a). However, fundamental rearing methods have remained largely unchanged. Despite more than two decades since the initial report on glass eel production, a clear path to mass production remains elusive.
Current methods for inducing ovulation in Japanese eels have transitioned from the use of the salmon pituitary gland to artificial hormones, enabling the stable acquisition of fertilized eggs (personal communications). However, two major challenges persist in larval breeding methods: the inability to rear large numbers of larvae simultaneously in large tanks and the slow growth rate. This study focuses on addressing the issue of slow growth and elucidates its underlying causes and mechanisms.
2. Growth and shape of the artificial leptocephalus
2.1. Standard growth of artificial leptocephalus
Japanese eel fertilized eggs obtained by salmon pituitary extract (Kawakami, 2022a, 2022b, 2023, Kawakami et al., 2012, 2013, 2014, Sudo et al., 2022) or recombinant Japanese eel follicle-stimulating hormone (Kazeto et al., 2019, 2021) produce hatchlings at 24-25°C in approximately 30-35 h. A large egg cavity characterizes eel fertilized eggs (
Figure 2). However, in artificially fertilized eggs, types with narrow egg cavities sometimes appear (arrows in
Figure 2) (Figure 5 in Kawakami et al., 2012), so the correlation between egg diameter and hatchling size is unclear. After hatching, larvae gradually change shape. The energy required for morphogenesis is provided by the egg yolk from the embryo, which is absorbed as the days pass (
Figure 3). Larvae begin to feed at late 6 to 7 days post hatching (dph) at 24-25°C. At that time, there was still a small amount of yolk or oil globules behind the heart (
Figure 3E). However, without timely feeding, the majority of these larvae usually do not survive beyond approximately 10 dph. Therefore, initiating feeding promptly is crucial.
The average total length (TL) of larvae at 7 dph ranged from 6 to 7 mm (
Figure 4).
Depending on the lots, there were cases where larvae in the 5 mm TL range occupied the majority (
Figure 4F). Growth tests have been conducted on 7 dph larvae with a target rearing period of 30 days (36 dph), and if the average TL at 7 dph is 7 mm TL, the average length at 36 dph may be approximately 11-13 mm TL (for example, Kawakami et al., 2014). The average daily growth rate from the first feeding day (7 dph) was 0.13-0.20 mm/day. At the end of 60 days of rearing (66 dph), the average TL may be in the range of 15-20 mm. The average daily growth rate from 7 dph was 0.13-0.22 mm/day, which falls within the previously reported range of 0.1-0.3 mm/day (Okamura, 2013b). Furthermore, in our reared leptocephali, the size range at the end of 120 days of rearing (126 dph) ranged from 30 to 43 mm TL. The daily growth rate ranged from 0.19 to 0.30 mm/day, suggesting that larger larvae experienced faster growth.
2.2. Growth and morphological shape of wild and artificial leptocephalus
Wild leptocephali are estimated to have a daily growth rate of 0.3-0.5 mm based on size and otolith daily increments (Okamura et al., 2013b). Moreover, based on the otolith daily increments data of Kawakami et al. (1998), we assume that the leptocephalus stage lasts for 120-150 days. In addition, we assume that the size of the first feeding larvae (7dph) is 7 mm TL, and the size of the larva at the start of metamorphosis is 60 mm TL. The reason for choosing 60 mm TL will be explained later. The growth rate of wild leptocephalus is 0.37-0.47 mm/day.Thus, wild leptocephalus is generally believed to exhibit a faster growth rate than artificial leptocephalus. In addition, when comparing the external morphology between wild and artificial leptocephalus, the differences are significant, especially in small-sized leptocephalus. The body depth (BD) of wild leptocephalus, for example, is already tall and the body shape is plump, even at a small size of 10 mm and/or 20 mm TL (
Figure 5) (for example, Mochioka et al., 1994). On the other hand, Tanaka et al. (2001) compared BD/TL between wild and artificial leptocephalus and found that the BD of artificial leptocephalus was clearly lower. We attribute this difference to the amount of hyaluronic acid (HA) stored in the body.
HA, a high-molecular-weight glycosaminoglycan component of extracellular matrices (Toole, 1990, Laurent and Fraser, 1992), accumulates in the body of leptocephali (Kawakami et al., 2009, 2014) and accounts for approximately 45% of the total body area of more than 50 mm TL (Kawakami, 2022b). Therefore, we consider that the amount of HA in the body may be involved in the body shape of leptocephali.
Figure 6 shows the change in BD of a leptocephali in captivity when it became unable to feed due to movement disorders. This leptocephalus could no longer feed adequately and died after approximately over 1 month (
Figure 6), while BD decreased. It is amazing that leptocephali survived for approximately one month without eating enough, but we expect that the main energy source for survival during that time was due to the triglyceride (TG) and/or HA that had accumulated up to that point (see Kawakami, 2022a, 2022b, Kawakami et al., 2008, 2014). In essence, leptocephali grow while accumulating HA. There was a significant difference in the efficiency of HA accumulation between wild and artificial leptocephali, which may be reflected in the distinct BD variations. In conclusion, BD is likely to be an important indicator for assessing the internal trophic level of the leptocephalus stage.
3. Growth strategies for artificial leptocephalus seen in seedling production
3.1. Artificial feed for rearing leptocephali
In 2002, Tanaka et al., (2003) reported the production of glass eel, but the bait used in that case was a paste based on North Pacific spiny dogfish (
Squalus suckleyi) eggs (
Figure 7A,B). North Pacific spiny dogfish are considered to be a highly abundant shark species (Yano et al., 2017a, 2017b); however, due to concerns about the depletion of resources, there has been a shift from eggs of North Pacific spiny dogfish to hen egg yolk (Okamura et al., 2013a; Tanaka et al., 2001, Tanaka et al., 2003). However, the hen egg yolk-based feed also did not change the properties of the shark egg-based diets.
Marine snow is considered a food source in wild leptocephalus (Miller et al., 2013). Little is known about its feeding ecology, however, we can predict its feeding ecology from the behavior patterns and morphology of artificial leptocephalus in captivity. First of all, leptocephali are not suitable for active swimming due to their low muscle mass (Kawakami 2022b). Therefore, leptocephali are unlikely to actively swim in the open ocean. Perhaps the depth of water that they inhabit is rich in organic matter, and it is an environment where they can always eat organic matter. In contrast, in artificial diets based on shark egg or hen egg yolk, feeding is stimulated by illumination. During this time, the leptocephali moved violently around the bottom of the tank (
Figure 7C,D).
Leptocephali also have a unique digestive tract. The digestive tract of leptocephali is called the rectum, and they do not yet have an organ called the stomach. Therefore, candidates for food are expelled within a short time after ingestion. In seedling production, we try to establish a feeding schedule of four and/or five times a day to allow for as much feeding time as possible, for example, 5 times a day at 2h intervals from 9 am to 5 pm (Kawakami, 2022a, 2022b, Kawakami et al., 2013, 2014), in other words, to ensure that food always stays in the rectum as long as possible.
Figure 8 shows a predicted model of the energy balance between energy uptake from feeding and energy expended in wild and artificial leptocephalus. The horizontal axis shows the same time. On the artificial leptocephalus side, four feeding times were set in between (gray area in
Figure 8A). Kinetic energy is consumed intensely during feeding time in artificial leptocephalus (red dots in
Figure 8A); however, once the feeding time is over and the lights are turned off, they gradually stop moving. We assume that leptocephali in the wild environment adopt a strategy to increase energy accumulation efficiency by constantly feeding while minimizing swimming behavior (green dots in
Figure 8B). On the other hand, the reason for the poor growth rate of artificial rearing is thought to be because artificial leptocephalus cannot be constantly fed (blue dots in
Figure 8A). Furthermore, the amount of energy available for growth is relatively small because the intense kinetic energy consumption during feeding (green dots in
Figure 8A). In addition, wild leptocephalus efficiently stores energy during growth and in the body, whereas artificial leptocephali cannot adequately take up energy. As a result, not only growth but also energy storage efficiency in the body is probably poor. The stored energy here refers to HA. We predict that poor HA accumulation efficiency is reflected in low BD (
Figure 5).
Marine snow, which is said to be eaten by leptocephali, is thought to be mainly composed of organic matter derived from phytoplankton (Tsukamoto and Miller, 2021). Therefore, it was hypothesized that growth was slow because of the high nutritional value of the artificial feed currently administered (personal communications). The main ingredients of the current artificial feed are animal ingredients; therefore, it differs from the original organic matter composition. However, we do not support this hypothesis. Various ingredients have been tried in the process leading up to the current feed development, but the addition of polymeric components clearly leads to slow growth and/or high mortality. Therefore, protein components in current feeds must be composed of low-molecular-weight peptides and/or amino acids (
Figure 7A) (for example, Tanaka et al., 2001). This phenomenon indicates that the digestive tract of leptocephali cannot sufficiently digest and absorb macromolecular components, which is largely due to the feeding ecology. In other words, because leptocephali feed on marine snow, they can grow even if their digestive functions are immature.
During metamorphosis, the posterior part of the rectum, which functions for digestion and absorption during the leptocephalus stage, disappears completely because of apoptosis (Kawakami 2023 Kawakami et al., 2013). From metamorphic larvae to elver (juvenile), a new digestive organ is formed in the anterior part of the rectum that can be observed in the leptocephalus stage, i.e., in the part before the last vertical blood vessel (Kawakami 2023). On the other hand, during the leptocephalus stage, the rectum also elongates as the size increases, however, there appears to be little change in digestive function from the first feeding larvae (6 or 7dph) to fully grown leptocephalus (Kawakami et al., 2013, Tanaka, 2003). Therefore, low-molecular-weight organic substances are essential as food for leptocephali, which is one of the reasons why so-called marine snow is considered a natural food candidate. Paradoxically, it is also possible that their digestive function did not develop because marine snow was the main food. In conclusion, to raise leptocephali efficiently, it is necessary to construct a rearing environment in which they can constantly eat low-molecular-weight feed.
3.2. Relationship between HA levels and leptocephalus growth
HA plays a role in adjusting specific gravity, facilitating planktonic life in the leptocephali stage (Kawakami 2022b), and is accumulated in the body as internal nutrition (Kawakami et al., 2009, 2014). We focused on HA synthesis-promoting substances (HASPS) and investigated whether the amount of HA in the body increased by adding it to the diet, and found that it increased significantly, moreover, a growth-promoting effect was also observed (Kawakami et al., 2014). Although the relationship between HA and growth is still hypothetical, the growth promotion associated with the addition of HASPS can be explained by the energy balance of leptocephalus larvae associated with the current feeding method. Leptocephali can store energy in the body in the form of HA. The main purpose of stocked energy is to use it as a necessary energy source during metamorphosis (Kawakami 2023). However, even if leptocephali are unable to feed for some reason, it is speculated that they have a strategy of compensating for the lack of metabolic energy by consuming accumulated HA. As described above, in the current feeding method for seedling production, the energy absorption efficiency fluctuates greatly over time and is not constant, and the energy loss due to exercise is large. Therefore, the amount of energy absorbed per day will be small compared with that in the wild environment (
Figure 8). The result is slow growth. Therefore, it is possible that they maintain their survival while metabolically degrading the stored HA at any time. In other words, a possible effect of HASPS is to increase the efficiency of energy absorption and/or storage from diets. By supplementing chronic energy shortages due to lack of food or excessive exercise energy consumption with stored energy, so-called HA, the amount of energy that should be devoted to growth may be relatively increased.
3.3. Metamorphosis size affected by leptocephalus growth retardation
Based on otolith daily increment analysis, wild leptocephalus metamorphoses in approximately 120-150 days (Kawakami et al., 1998, 1999a, 1999b). During the metamorphosis process from leptocephali to glass eels, the TL of the larvae shrinks. Therefore, because the average TL of wild glass eels collected on the Pacific coast of Japan in 2014 was approximately 61 mm TL, the starting size of metamorphosis in wild leptocephalus is expected to be approximately 60 mm TL or more (
Figure 9) (Kawakami, 2023). According to previous findings, the average size of wild glass eels collected on the Japan Sea coast of Japan was approximately 58-59 mm TL (Kawakami et al., 1998, 1999a). The area where Japanese eels begin metamorphosis is estimated to be off the coast of Taiwan, but the Pacific coast is influenced by the Kuroshio Current, which is a strong current. On the other hand, the migration route on the Japan Sea side is more complicated, as the glass eels are thought to switch from the Kuroshio Current to the Tsushima Current in the East China Sea (Kawakami et al., 1999a, 1999b). Therefore, the number of immigration days in the glass eel stage is longer than that on the Pacific coast (Kawakami et al., 1999b). In other words, what we want to say is that the longer the number of immigration days of the glass eel stage, the smaller the size of the glass eels gradually and finish metamorphosis to elver (juvenile) finally. Complementing this phenomenon,
Figure 8 shows the size transition from leptocephali to glass eel and then to elver (juvenile) by early metamorphosis induction using T
4 (Kawakami, 2023). The size reduction during metamorphosis from approximately 40 mm TL leptocephali to elver is obvious. These phenomena are also examples that prove that glass eels correspond to the metamorphic stage.
On the other hand, in artificial rearing, leptocephali that metamorphose when they reach 50 mm TL or larger, so-called fully grown leptocephali, can be seen and are defined as being of a metamorphosable size (Kawakami et al., 2013, Tanaka, 2003). In other words, this phenomenon means that the size of metamorphosed artificial glass eels is between the latter half of 40 mm and the first half of 50 mm TL because of TL involution (Kawakami, 2023). So far, we have reported 52.7 mm TL wild glass eels as the smallest size in northern Kyushu, Japan (Kawakami et al.,1999a), but we have rarely seen wild Japanese glass eels around 50 mm in size. In other words, artificial glass eels are usually smaller than wild glass eels.
The reason for this smaller size is the slow growth of artificial leptocephalus using conventional seedling production methods. In other words, a natural growth rate of 60 mm TL or more in 120-150 days cannot be achieved in the case of seedling production. Therefore, the artificial leptocephalus itself judged that the possibility of reaching a 60 mm TL in the future was low, i.e., a time limit, and gave up on growth and chose metamorphosis. We propose the "time-limit theory" for the phenomenon of the production of miniaturized glass eels, which is currently recognized in artificial seedlings. In other words, the artificial leptocephali are probably stressed because they have spent more time than planned for growth. In addition, it is thought that the start of the metamorphosing size of leptocephali has decreased because it has switched from growth to metamorphosis, indicating that it is impossible for it to grow further and reach the metamorphosis size of 60 mm.
3.4. Stress during the leptocephalus period
During breeding, cases of brain clouding are sometimes observed in artificial leptocephali, particularly in large leptocephali (). In some cases, the brain heals as it is, but most of them die when it becomes cloudy. The cause of this phenomenon is still unknown. We have noted that this phenomenon is observed only in large individuals, and we suspect that stress due to growth retardation may be the main cause. The purpose of leptocephali is to store enough energy in the body for metamorphosis into juveniles, and the target size is 60 mm or more (Kawakami, 2023). In the wild, however, the migration path and timing of metamorphosis are controlled by the constant, North Equatorial Current (
Figure 1), and it is presumed that they are programed to complete the accumulation of nutrients quickly. Against this background, the slow growth rate in seedling production is a major problem for leptocephali, and they are probably stressed. To compensate for such growth delays, the leptocephali may have found a strategy for miniaturizing metamorphosis initiation size.
4. Concerns about the future Japanese eel seedling production
More than 30 years have already passed since research and development on Japanese eel seedling production began in earnest in Japan. However, other than HASPS (Kawakami et al., 2014) and the early metamorphosis induction method (Kawakami, 2023) that we developed, no effective method to solve growth retardation has been established. Until now, Japanese eel seedling production development has focused on acquiring stable seedling production development technology (Okamura et al., 2013b, 2019, Tanaka 2015), but now the main focus is on acquiring mass production technology. In the future, it is possible that, for example, through breeding improvement and genome editing (Kinoshita et al., 2018), varieties that emphasize rapid growth in the larval stage will be established to catch up on the past delays. The development of these fast-growing varieties has been reported in the field of aquaculture, for example, rainbow trout (Oncorhynchus mykiss) (Paaver et al., 2004) and red sea bream (Pagrus major) (Murata et al., 1996), and is therefore a common subject of research in fisheries. The development of such breeds for Japanese eels is also a subject of research, but as of now, no one has understood the future problems.
The life history of Japanese eel larvae is influenced by the North Equatorial Current (Kawakami et al., 1999a), and their growth rate is probably determined by following a certain current velocity. In particular, the migratory pattern of glass eels that migrate to the coast of Japan requires at least three factors to function stably: the growth rate of leptocephalus in the North Equatorial Current, the sea area where metamorphosis begins, and the timing of switching to the Kuroshio Current (
Figure 1).Therefore, if varieties specialized for larval growth were created and spread uncontrollably, the life cycle of Japanese eel could be disrupted. In other words, if the sea area where they reach the metamorphosable size shifts to eastward and/or southward from before, there is a high possibility that it will affect their subsequent immigration behavior. In conclusion, to maintain stable immigration, risk management, such as avoiding the genetic pollution (Cognetti et al., 2006, Kang et al., 2023) is necessary.
5. Conclusions
In this study, we investigated why the current Japanese eel seedling production method, which differs greatly from the natural feeding ecology, is unable to satisfy the growth of leptocephalus. The main reason for this can be explained by the small amount of energy taken in from food and the high amount of kinetic energy consumed due to excessive exercise during feeding. As a result, artificial leptocephalus grows slower than the wild, failing to reach the original goal of 60 mm TL and over within the specified time, and the starting size of metamorphosis is smaller. Although our hypothesis regarding time stress during larval rearing requires further investigation, it underscores the importance of exploring stress-related factors in larval rearing to improve seedling production practices in the future.
Acknowledgments
This study was partly supported by Shin Nippon Biomedical Laboratories, Ltd workers.
Conflicts of Interest
The authors declare no conflict of interest.
References
- Cognetti, G.; Maltagliati, F.; Saroglia, M. The risk of" genetic pollution" in Mediterranean fish populations related to aquaculture activities. Marine Pollution Bulletin 2006, 52, 1321–1323. [Google Scholar] [CrossRef] [PubMed]
- Ijiri, S.; Tsukamoto, K.; Chow, S.; Kurogi, H.; Adachi, S.; Tanaka, H. Controlled reptoduction in the Japanese eel (Anguilla japonica), past and present. Aquaculture Europe 2011, 36, 13–17. [Google Scholar]
- Kang, B.; Vitule, J. R.; Li, S.; Shuai, F.; Huang, L.; Huang, X.; Fang, J.; Shi, X.; Zhu, Y.; Xu, D.; Yan, Y.; Lou, F. Introduction of non-native fish for aquaculture in China: A systematic review. Reviews in Aquaculture 2023, 15, 676–703. [Google Scholar] [CrossRef]
- Kawakami, Y. Metabolism of a hyaluronic acid during early development of Japanese eel (Anguilla japonica). Comp. Biochem. Physiol. A 2022a, 268, 111203. [Google Scholar] [CrossRef] [PubMed]
- Kawakami, Y. Characterization of triglycerides during early development of the Japanese eel (Anguilla japonica). Comp. Biochem. Physiol. A 2022b, 265, 111125. [Google Scholar] [CrossRef] [PubMed]
- Kawakami, Y. Sensitivity of Anguilliformes leptocephali to metamorphosis stimulated by thyroid hormone depends on larval size and metamorphic stage. Comp. Biochem. Physiol. A. 2023, 276, 111339. [Google Scholar] [CrossRef] [PubMed]
- Kawakami, Y.; Mochioka, N.; Nakazono, A. Immigration period and age of Anguilla japonica glass eels entering rivers in northern Kyushu, Japan during 1994. Fish. Sci. 1998, 64, 235–239. [Google Scholar]
- Kawakami, Y.; Mochioka, N.; Nakazono, A. Immigration patterns of glass eels Anguilla japonica entering river in Northern Kyushu, Japan. Bull. Mar. Sci. 1999a, 64, 315–327. [Google Scholar]
- Kawakami, Y.; Mochioka, N.; Kimura, R.; Nakazono, A. Seasonal changes of the RNA/DNA ratio, size and lipid contents and immigration adaptability of Japanese glass eels, Anguilla japonica, collected in northern Kyushu, Japan. J. Exp. Mar. Biol. Ecol. 1999b, 238, 1–19. [Google Scholar] [CrossRef]
- Kawakami, Y.; Oku, H.; Nomura, K.; Gorie, S.; Ohta, H. Metabolism of a glycosaminoglycan during metamorphosis in the Japanese conger eel, Conger myriaster. Biochem. Res. Int. 2009, 251731. [Google Scholar] [CrossRef]
- Kawakami, Y.; Ishihara, M.; Saito, T.; Fujimoto, T.; Adachi, S.; Arai, K.; Yamaha, E. Cryopreservation of green fluorescent protein (GFP)-labeled primordial germ cells with GFP fused to the 3’ untranslated region of the nanos gene by vitrification of Japanese eel (Anguilla japonica) somite stage embryos. J. Anim. Sci. 2012, 90, 4256–4265. [Google Scholar] [CrossRef] [PubMed]
- Kawakami, Y.; Nomura, K.; Ohta, H.; Tanaka, H. Characterization of thyroid hormone receptors during early development of the Japanese eel (Anguilla japonica). Gen. Comp. Endocrinol. 2013, 194, 300–310. [Google Scholar] [CrossRef] [PubMed]
- Kawakami, Y.; Nomura, K.; Tanaka, H. Growth promoting effect of hyaluronan synthesis promoting substances on Japanese eel leptocephali. PLoS One 2014, 9, e98688. [Google Scholar] [CrossRef] [PubMed]
- Kazeto, Y.; Tanaka, T.; Suzuki, H.; Ozaki, Y.; Fukada, H.; Gen, K. Development and validation of enzyme-linked immunosorbent assays specific for follicle-stimulating hormone and luteinizing hormone in Japanese eel. Fish. Sci. 2019, 85, 829–837. [Google Scholar] [CrossRef]
- Kazeto, Y.; Suzuki, H.; Ozaki, Y.; Gen, K. C-terminal peptide (hCTP) of human chorinic gonadotropin enhances in vivo biological activity of recombinant Japanese eel follicle-stimulating hormone and luteinzing hormone produced in FreeStyle 293-F cell lines. Gen. Comp. Endocrinol. 2021, 306, 113731. [Google Scholar] [CrossRef] [PubMed]
- Kishimoto, K.; Washio, Y.; Yoshiura, Y.; Toyoda, A.; Ueno, T.; Fukuyama, H.; Kato, K.; Kinoshita, M. Production of a breed of red sea bream Pagrus major with an increase of skeletal muscle mass and reduced body length by genome editing with CRISPR/Cas9. Aquaculture 2018, 495, 415–427. [Google Scholar] [CrossRef]
- Laurent, T.C.; Fraser, J.R. Hyaluronan. FASEB J. 1992, 6, 2397–2404. [Google Scholar] [CrossRef] [PubMed]
- Miller, M.J.; Chikaraishi, Y.; Ogawa, N.O.; Yamada, Y.; Tsukamoto, K.; Ohkouchi, N. A low trophic position of Japanese eel larvae indicates feeding on marine snow. Biol. Lett. 2013, 9, 20120826. [Google Scholar] [CrossRef] [PubMed]
- Mochioka, N.; Otake, T.; Tsukamoto, K. Preliminary report of the Hakuho Maru cruise KH-91-4. 1994; pp. 28–36. (in Japanese).
- Murata, O.; Harada, T.; Miyashita, S.; Izumi, K. I.; Maeda, S.; Kato, K.; Kumai, H. Selective breeding for growth in red sea bream. Fish. Sci. 1996, 62, 845–849. [Google Scholar] [CrossRef]
- Nelson, J.S. Fish of the World; Wiley: New York, 2006. [Google Scholar]
- Okamura, A.; Yamada, Y.; Horie, N.; Mikawa, N.; Tanaka, S.; Kobayashi, H.; Tsukamoto, K. Hen egg yolk and skinned krill as possible foods for rearing leptocephalus larvae of Anguilla japonica Temminck & Schlegel. Aquaculture 44, 1531–1538.
- Okamura, A.; Horie, N.; Mikawa, N.; Yamada, Y.; Tsukamoto, K. Recent advances in artificial production of glass eels for conservation of anguillid eel populations. Ecol. Freshw. Fish 23, 95–110. [CrossRef]
- Okamura, A.; Yamada, Y.; Horie, N.; Mikawa, N.; Tsukamoto, K. Long-term rearing of Japanese eel larvae using liquid-type diet: food intake, survival and growth. Fish. Sci. 2019, 85, 687–694. [Google Scholar] [CrossRef]
- Paaver, T.; Gross, R.; Ilves, P. Growth rate, maturation level and flesh quality of three strains of large rainbow trout (Oncorhynchus mykiss) reared in Estonia. Aquaculture International 2004, 12, 33–45. [Google Scholar] [CrossRef]
- Pfeiler, E.; Toyoda, H.; Williams, M.D.; Nieman, R.A. Identification, structural analysis and function of hyaluronan in developing fish larvae (leptocephali). Comp. Biochem. Physiol. B 2002, 132, 443–451. [Google Scholar] [CrossRef] [PubMed]
- Sudo, R.; Kawakami, Y.; Nomura, K.; Tanaka, H. Production of recombinant Japanese eel (Anguilla japonica) growth hormones and their effects on early-stage larvae. Gen. Comp. Endocrinol. 2022, 317, 113977. [Google Scholar] [CrossRef] [PubMed]
- Tanaka, H. Techniques for larval rearing. In Eel Biology; Aida, K., Tsukamoto, K., Yamauchi, K., Eds.; Blackwell Publishing Asia: Melbourne, 2003; pp. 427–434. [Google Scholar]
- Tanaka, H. Progression in artificial seeding production of Japanese eel Anguilla japonica. Fish. Sci. 2015, 81, 11–19. [Google Scholar] [CrossRef]
- Tanaka, H.; Kagawa, H.; Ohta, H. Production of leptocephali of Japanese eel (Anguilla japonica) in captivity. Aquaculture 2001, 201, 51–60. [Google Scholar] [CrossRef]
- Tanaka, H.; Kagawa, H.; Ohta, H.; Unuma, T.; Nomura, K. The first production of glass eel in captivity: fish reproductive physiology facilitates great progress in aquaculture. Fish. Physiol. Biochem. 2003, 28, 493–497. [Google Scholar] [CrossRef]
- Tesch, F.W. The Eel; Chapman & Hall: New York, NY, 1977. [Google Scholar]
- Toole, B.P. Hyaluronan and its binding proteins, the hyaladherins. Curr. Op. Cell Biol. 1990, 2, 839–844. [Google Scholar] [CrossRef]
- Tsukamoto, K. Discovery of the spawning area for the Japanese eel. Nature 1992, 356, 789–791. [Google Scholar] [CrossRef]
- Tsukamoto, K.; Miller, M.J. The mysterious feeding ecology of leptocephali: a unique strategy of consuming marine snow materials. Fish. Sci. 2021, 87, 11–29. [Google Scholar] [CrossRef]
- Yamamoto, K.; Yamauchi, K. Sexual maturation of Japanese eel and production of eel larvae in the aquarium. Nature 1974, 251, 220–222. [Google Scholar] [CrossRef] [PubMed]
- Yano, T.; Ohshimo, S.; Kanaiwa, M.; Hattori, T.; Fukuwaka, M. A.; Nagasawa, T.; Tanaka, S. Spatial distribution analysis of the North Pacific spiny dogfish, Squalus suckleyi, in the North Pacific using generalized additive models. Fish. Oceanography 2017a, 26, 668–679. [Google Scholar] [CrossRef]
- Yano, T.; Hattori, T.; Tamukai, T.; Ohshimo, S. Body-length frequency and spatial segregation of the North Pacific spiny dogfish Squalus suckleyi in Tsugaru Strait, northern Japan. Fish. Sci. 2017b, 83, 917–928. [Google Scholar] [CrossRef]
Figure 1.
Location of glass-eel, Anguilla japonica, sampling stations and site of glass-eel and metamorphosing leptocephalus collection in open sea (for example, described of Kawakami et al., 1999). Red arrows: North Equatorial Current and Mindanano Current. Apricot arrow: Kuroshio current. Purple arrow: Tsushima current. Star: Spawning cite. Yellow cercles: metamorphosing leptocephalus. Blue squares: glass eel. Cream area: Estimated distribution area of metamorphosing leptocephalus. Blue arrows: Dispersion direction of glass eels.
Figure 1.
Location of glass-eel, Anguilla japonica, sampling stations and site of glass-eel and metamorphosing leptocephalus collection in open sea (for example, described of Kawakami et al., 1999). Red arrows: North Equatorial Current and Mindanano Current. Apricot arrow: Kuroshio current. Purple arrow: Tsushima current. Star: Spawning cite. Yellow cercles: metamorphosing leptocephalus. Blue squares: glass eel. Cream area: Estimated distribution area of metamorphosing leptocephalus. Blue arrows: Dispersion direction of glass eels.
Figure 2.
Artificial blastocyst eggs of Japanese eel (Anguilla japonica). Arrows indicate eggs with narrow perivitelline spaces.
Figure 2.
Artificial blastocyst eggs of Japanese eel (Anguilla japonica). Arrows indicate eggs with narrow perivitelline spaces.
Figure 3.
Yolk sac found in artificial early larvae (Anguilla japonica). A: 0 day post hatching (dph), B: 1 dph, C: 3dph, D: 5 dph, E: 7 dph larvae. Arrows indicate yolk sac and oil globule.
Figure 3.
Yolk sac found in artificial early larvae (Anguilla japonica). A: 0 day post hatching (dph), B: 1 dph, C: 3dph, D: 5 dph, E: 7 dph larvae. Arrows indicate yolk sac and oil globule.
Figure 4.
Total length (TL) distribution of 7 dph artificial larvae (Anguilla japonica). A,B,C,D: Average size. E: Large size. F: Small size.
Figure 4.
Total length (TL) distribution of 7 dph artificial larvae (Anguilla japonica). A,B,C,D: Average size. E: Large size. F: Small size.
Figure 5.
Comparison of body shapes of wild and artificial small leptocephalus (Anguilla japonica). A: Wild leptocephalus (12.3 mm TL) from Mochioka et al. (1994). B: Artificial leptocephalus (12.7 mm TL).
Figure 5.
Comparison of body shapes of wild and artificial small leptocephalus (Anguilla japonica). A: Wild leptocephalus (12.3 mm TL) from Mochioka et al. (1994). B: Artificial leptocephalus (12.7 mm TL).
Figure 6.
Size change of the artificial leptocephalus (Anguilla japonica) (26.5 mm TL) that can no longer eat due to movement disorders. TL: total length, BD: body depth.
Figure 6.
Size change of the artificial leptocephalus (Anguilla japonica) (26.5 mm TL) that can no longer eat due to movement disorders. TL: total length, BD: body depth.
Figure 7.
Artificial leptocephalus (Anguilla japonica) consuming shark egg bait. A: Bait material. Frozen shark eggs are on the far right. B: Shark egg bait, C, D: Leptocephali feeding situation.
Figure 7.
Artificial leptocephalus (Anguilla japonica) consuming shark egg bait. A: Bait material. Frozen shark eggs are on the far right. B: Shark egg bait, C, D: Leptocephali feeding situation.
Figure 8.
Changes in the regression rate of artificial leptocephalus (Anguilla japonica) induced to undergo metamorphosis by T4. Lepto: around 40 mm TL leptocephali (40.3-44.5 mm TL), Glass eel: Stage 4 (VA) as defined in Kawakami et al., 2013, Elver: Juvenile.
Figure 8.
Changes in the regression rate of artificial leptocephalus (Anguilla japonica) induced to undergo metamorphosis by T4. Lepto: around 40 mm TL leptocephali (40.3-44.5 mm TL), Glass eel: Stage 4 (VA) as defined in Kawakami et al., 2013, Elver: Juvenile.
Figure 9.
Schematic diagram of energy metabolism in wild and artificially reared leptocephalus. A: Wild leptocephalus in open sea. B: Artificial leptocephalus in a recent breeding system. Green circles: Total energy, which is represents the amount of energy stored in the body. Blue circles: Energy intake from food. Red circles: Physical energy. Gray area: Feeding time.
Figure 9.
Schematic diagram of energy metabolism in wild and artificially reared leptocephalus. A: Wild leptocephalus in open sea. B: Artificial leptocephalus in a recent breeding system. Green circles: Total energy, which is represents the amount of energy stored in the body. Blue circles: Energy intake from food. Red circles: Physical energy. Gray area: Feeding time.
Figure 10.
Artificial leptocephalus (Anguilla japonica) with a cloudy brain. A: Metamorphosing leptocephalus (52 mm TL) B: Leptocephali (43 mm TL).
Figure 10.
Artificial leptocephalus (Anguilla japonica) with a cloudy brain. A: Metamorphosing leptocephalus (52 mm TL) B: Leptocephali (43 mm TL).
|
Disclaimer/Publisher’s Note: The statements, opinions and data contained in all publications are solely those of the individual author(s) and contributor(s) and not of MDPI and/or the editor(s). MDPI and/or the editor(s) disclaim responsibility for any injury to people or property resulting from any ideas, methods, instructions or products referred to in the content. |
© 2023 by the authors. Licensee MDPI, Basel, Switzerland. This article is an open access article distributed under the terms and conditions of the Creative Commons Attribution (CC BY) license (http://creativecommons.org/licenses/by/4.0/).